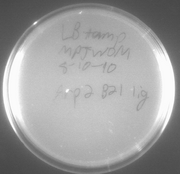
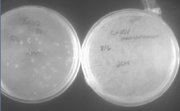
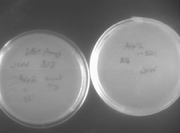
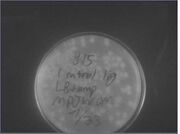
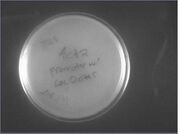
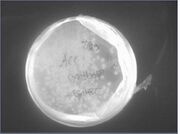
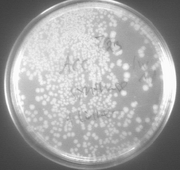
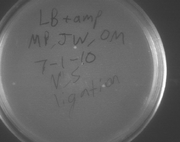
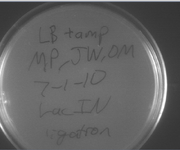
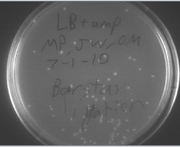

Uploads by Julia C. Winn
From OpenWetWare
Jump to navigationJump to search
This special page shows all uploaded files.
| Date | Name | Thumbnail | Size | Description |
|---|---|---|---|---|
| 14:49, 11 August 2010 | Arp2coloniesligb21.jpg (file) | |
200 KB | |
| 14:46, 11 August 2010 | 810digestslater.jpg (file) |  |
132 KB | |
| 19:58, 9 August 2010 | 89moredigestspm.jpg (file) |  |
178 KB | |
| 13:24, 9 August 2010 | 88 other digests.jpg (file) |  |
136 KB | |
| 13:23, 9 August 2010 | 86 digests.jpg (file) |  |
115 KB | |
| 13:22, 9 August 2010 | 88yescamvexp2.jpg (file) | |
254 KB | |
| 13:19, 9 August 2010 | 88noarp2.jpg (file) | |
264 KB | |
| 20:02, 26 July 2010 | 726arapcregel.jpg-px240 (file) |  |
154 KB | |
| 13:45, 26 July 2010 | B15 Control Lig 7-23.jpg (file) | |
13 KB | |
| 13:44, 26 July 2010 | Barnase 1+2 Strep lig 7-23.jpg (file) |  |
17 KB | |
| 13:43, 26 July 2010 | Act2lacO Lig 7-23.jpg (file) | |
13 KB | |
| 13:43, 26 July 2010 | B21 Control Lig 7-23.jpg (file) |  |
14 KB | |
| 13:42, 26 July 2010 | Gal4DBD Lig 7-23.jpg (file) |  |
14 KB | |
| 13:42, 26 July 2010 | NLS.Serine lig 7-23.jpg (file) |  |
14 KB | |
| 13:28, 26 July 2010 | ACC linker lig 7-23.jpg (file) | |
16 KB | |
| 13:23, 26 July 2010 | 5xGalpt Lig 7-23.jpg (file) |  |
14 KB | |
| 12:49, 26 July 2010 | 725failgel.jpg (file) |  |
139 KB | |
| 12:46, 26 July 2010 | 725act2.jpg (file) |  |
164 KB | |
| 12:45, 26 July 2010 | 725acc.jpg (file) | |
192 KB | |
| 21:44, 22 July 2010 | 722pcrexp2sucess2.jpg (file) |  |
58 KB | |
| 21:43, 22 July 2010 | 722pcrexp2sucess.jpg (file) |  |
196 KB | |
| 18:45, 22 July 2010 | GrabsequenceGALDBDalign.jpg (file) |  |
127 KB | |
| 19:05, 16 July 2010 | 716pcrnewdnafail.jpeg (file) |  |
215 KB | |
| 18:02, 14 July 2010 | 714failarppcr.jpeg (file) |  |
137 KB | |
| 18:01, 14 July 2010 | 714failexpcr.jpeg (file) |  |
120 KB | |
| 15:19, 14 July 2010 | Dragon.jpeg (file) |  |
14 KB | |
| 15:06, 14 July 2010 | 713gelyeastcutout.jpeg (file) |  |
154 KB | |
| 15:06, 14 July 2010 | 713gelyeastbackbone.jpeg (file) |  |
156 KB | |
| 13:39, 9 July 2010 | 78gelextractskeleton.pdf (file) |  |
108 KB | |
| 15:51, 8 July 2010 | 78PCRgelGalBarnaseLac.pdf (file) |  |
93 KB | |
| 18:56, 7 July 2010 | Pdkintron.jpg (file) |  |
13 KB | pdk intron |
| 18:26, 7 July 2010 | 77LacINpcr.pdf (file) |  |
110 KB | |
| 18:22, 7 July 2010 | 77barstarnlsdigest1.pdf (file) |  |
119 KB | |
| 20:02, 6 July 2010 | 71NLSplateligase.pdf (file) | |
758 KB | |
| 19:59, 6 July 2010 | 71Lacplateligase.pdf (file) | |
821 KB | |
| 19:56, 6 July 2010 | 71barstarplateligate.pdf (file) | |
849 KB | |
| 19:53, 6 July 2010 | 71b21controlcolonies.pdf (file) |  |
827 KB | |
| 20:57, 2 July 2010 | 71barnasepcrweird.jpg (file) |  |
671 KB | |
| 14:05, 25 June 2010 | 624secondattempt.jpg (file) |  |
2.83 MB | |
| 19:51, 24 June 2010 | Failgel624.jpg (file) |  |
3.02 MB | |
| 13:48, 23 June 2010 | Cutout622.jpg (file) |  |
188 KB | |
| 13:45, 23 June 2010 | File.jpg (file) |  |
131 KB |